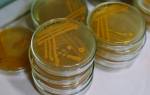

Каждый человек сталкивается с необходимостью сдачи анализов, и это происходит не раз в жизни. Мы проходим через этот этап, когда устраиваемся на новую работу, когда заболеваем, когда нужно пройти плановый осмотр, или когда хотим узнать, как обстоят дела со здоровьем.
Проводится анализ крови, мочи, лимфы и многих других показателей, но когда речь идет о заболеваниях, вызванных паразитами, заболеваниях печени, желудка и кишечника, тогда необходимо провести анализ кала. Однако для этого необходимо правильно подготовиться, знать количество и правильное питание перед сдачей анализа.
Подготовка к копрограмме
Возникает вопрос, можно ли питаться перед проведением копрограммы? Разумеется, можно, однако следует избегать употребления пищи, которая может повлиять на результаты исследования. Например, не рекомендуется употреблять красящие продукты, такие как свекла, а также продукты, способные вызвать расстройство желудка, поскольку для анализа необходима плотная консистенция кала. Также стоит воздержаться от приема лекарств и биологически активных добавок, а также не употреблять активированный уголь.
Наилучшим вариантом будет собрать фекалии утром, заранее подготовив для этого контейнер, который должен быть чистым и плотно закрывающимся. Такие емкости можно приобрести в любой аптеке, главное, чтобы фекалии не соприкасались с посторонними поверхностями (например, стенками унитаза), так как это может повлиять на результат анализа. Для сбора фекалий следует использовать специальную палочку или лопаточку, которые также можно приобрести в аптеке, не стоит пытаться изготавливать их самостоятельно.
Количество и особенности сбора анализа взрослого
У взрослого человека количество кала составляет до 15 грамм, что примерно соответствует размеру фисташки. Необходимо взять образцы из разных частей для анализа на наличие глистов. Если обнаружены кровянистые выделения или слизь, это может свидетельствовать о серьезных отклонениях от нормы. Для проведения анализа необходимо взять именно этот участок кала.
Также стоит отметить, что женщинам, находящимся в период менструации, рекомендуется воздержаться от сдачи анализов или использовать тампон во время процедуры.
Процесс сбора кала взрослого
- Для того чтобы провести анализ, необходимо либо собрать образец фекалий на чистый лист бумаги или в специальную емкость, чтобы в последствии легко собрать материал без посторонних примесей.
- Использовать специальные инструменты для сбора образца.
- Также может потребоваться взять анальный соскоб, который также можно взять дома, используя ленту и стеклянный слайд. Анальный соскоб обычно делается для проверки на наличие паразитов, в частности, глистов.
Абсолютно запрещено замораживать продукт и долго хранить его в холодильнике, максимальное время хранения кала — 12 часов. После этого необходимо собрать новый образец или сдать его в лабораторию. Важно плотно закрыть контейнер, чтобы исключить возможность попадания посторонних веществ.
С взрослыми все просто и не требуется никаких дополнительных усилий для контроля правильности сбора, но когда речь идет о детях, имеются определенные тонкости, на которые стоит обратить особое внимание.
Как собрать анализ у ребенка?
Прежде всего, для проведения процедуры потребуется горшок, который следует тщательно промыть и высушить.
- Необходимо помыть ребенка тщательно утром, вместо использования подмывания.
- Важно следить за тем, чтобы кал не смешивался с мочой.
- Для точного определения дефектов в лаборатории достаточно взять одну-две ложечки кала у ребенка.
Не стоит питать детей специальной пищей или вводить в рацион новые продукты, которые они не употребляют ежедневно. Лучше давать знакомую еду. Если ребенок испытывает проблемы с туалетом, не следует применять клизму, а лучше подождать некоторое время или отложить сдачу анализов до восстановления нормального состояния или взять образец вечером. Для анализа достаточно собрать 12-15 грамм сформированного кала.
Если показалось, что с ребенком имеются сложности, то это пустяки по сравнению со сбором у совсем маленьких детей — грудничков. Имеются некоторые трудности, но они преодолимы при определенной подготовке и представлении как осуществляется процесс.
Сбор кала грудничка и необходимое количество
Качество исследования может быть существенно затронуто качеством питания матери и ее образом жизни. Поэтому важно, чтобы матери воздерживались от употребления потенциально аллергенных продуктов, таких как клубника, за три дня до сдачи анализов, чтобы гарантировать точность результатов. Также, если у грудничка был жидкий стул, то рекомендуется отложить сдачу образца и принять ожидающую тактику.
Для проведения анализа необходимо, чтобы младенец сходил в памперс, после чего собрать несколько ложечек экскрементов в специальную баночку. Важно помнить, что необходимо собирать только верхний слой экскрементов, не соскабливая. Точное количество необходимого материала сложно определить заранее, поэтому следует предоставить в лабораторию все, что удалось собрать.
Однако перед тем, как провести анализы, необходимо следовать определенным правилам подготовки к их сбору:
- Приобретайте только обычные продукты за три дня до процедуры.
- Избегайте применения слабительных средств, все должно происходить естественным образом, в крайнем случае, перенесите исследование.
- Используйте исключительно стерильные баночки.
- Прекратите употребление различных витаминов и лекарств.
Как сдавать в лабораторию?
После того, как необходимое количество фекалий собрано в контейнер, необходимо на чистом листе бумаги небольшого размера записать полное имя и дату рождения человека, чей образец собран, и прикрепить к стенке емкости с помощью скотча. В лаборатории проводится анализ в течение суток, поэтому результаты будут доступны в кратчайшие сроки.
Что же в итоге может показать анализ?
Если обнаружены глисты, то все члены семьи должны сдать анализ кала и пройти лечение. Также в кале могут быть обнаружены следы крови, что может указывать на проблемы с желудочно-кишечным трактом, начиная от гастрита и заканчивая раком желудка. Поэтому важно не откладывать лечение и обратиться к врачам. Копрограмма может также выявить воспалительные процессы по наличию белка, а также показать наличие анемии, если у человека часто бывают головокружения и он постоянно чувствует себя слабым; выявить различные кишечные инфекции; выявить нарушения работы поджелудочной железы и наличие желчекаменной болезни.
В случае возникновения любых отклонений в результатах анализов, рекомендуется обратиться к вашему лечащему врачу для получения дальнейших рекомендаций.
Частые вопросы
Каково количество кала, необходимое для анализа, и как его сдавать?
Для анализа кала обычно требуется около 5-10 граммов. Лучше всего собирать утренний кал в чистый сухой контейнер, избегая при этом попадания мочи или воды. Затем следует доставить образец в лабораторию в течение нескольких часов для анализа.
Какие моменты стоит учесть при сдаче кала на анализ?
При сдаче кала на анализ важно избегать приема лекарств, которые могут исказить результаты, если это возможно. Также следует обратить внимание на индивидуальные рекомендации врача или лаборатории относительно диеты или приема пробиотиков перед сбором образца.
Полезные советы
СОВЕТ №1
Для анализа кала достаточно собрать примерно 5-10 граммов материала. Это обычно соответствует примерно одной чайной ложке.
СОВЕТ №2
Для более точных результатов рекомендуется собирать кал с разных участков, чтобы получить более полное представление об общем состоянии желудочно-кишечного тракта.
СОВЕТ №3
Перед сбором кала необходимо тщательно вымыть руки и использовать чистый контейнер для сбора материала. Важно избегать попадания посторонних веществ в образец.